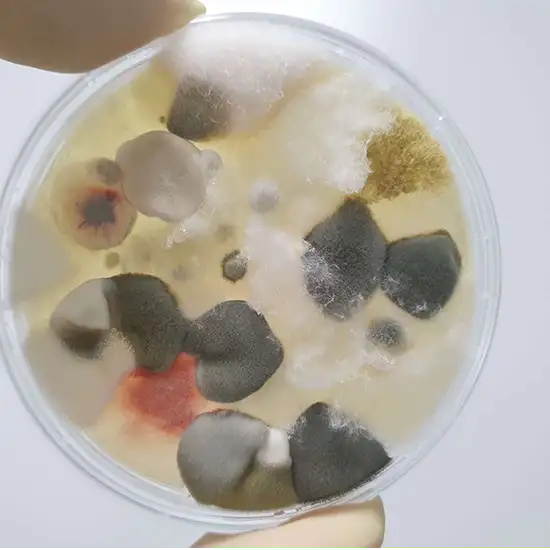

Book Fungal Culture Blood Appointment Online Near me at the best price in Delhi/NCR from Ganesh Diagnostic. NABL & NABH Accredited Diagnostic centre and Pathology lab in Delhi offering a wide range of Radiology & Pathology tests. Get Free Ambulance & Free Home Sample collection. 24X7 Hour Open. Call Now at 011-47-444-444 to Book your Fungal Culture Blood at 50% Discount.
A fungal culture test is used to help diagnose fungal infections. If you are exposed to fungi, you may develop fungal infections.
A fungal culture test is frequently performed to ascertain whether the fungus is present in the area that is afflicted, to identify the specific fungus, and to select the best course of therapy. The most prevalent fungus-related infection is ringworm, which is more common than most others. Heat, dampness, and skin abrasions are common causes of this infection, as well as all other fungus-related infections.
Why fungal culture test done?
No particular type of care is required, just leave your dressing strip on for at least 15 minutes.
The Fungal culture test price varies from INR 300 to INR 500 based on the location and the facility of the diagnostic center. You can book your Fungal culture blood test at home in Delhi with ganesh diagnostic center and get a discount of up to 50% off.
Choose the Top pathology lab for the Fungal culture test in Delhi NCR
| Test Type | Fungal Culture Blood |
| Includes | Fungal Culture Blood Test (Pathology Test) |
| Preparation | |
| Reporting | Within 24 hours* |
| Test Price |
₹ 350
|

Fungal Culture blood test checks for the presence of fungal infection in a body. Fungal infection symptoms are itching, redness, swelling, high fever, etc.
Before choosing the top diagnostic center make sure that the diagnostic center is accredited with NABL, provides pathology test at discounted prices, equipped with the latest technology with 100% accurate results guaranteed
There are no risks associated with a Fungal culture test
The Fungal culture test price in Delhi depends on the location and the reputation of the pathology lab. You can book your Fungal culture test in Delhi with ganesh diagnostic center and get a discount of up to 50% off.
You can type Fungal culture test near me in Google search for the nearest centers available in Delhi NCR.
Early check ups are always better than delayed ones. Safety, precaution & care is depicted from the several health checkups. Here, we present simple & comprehensive health packages for any kind of testing to ensure the early prescribed treatment to safeguard your health.